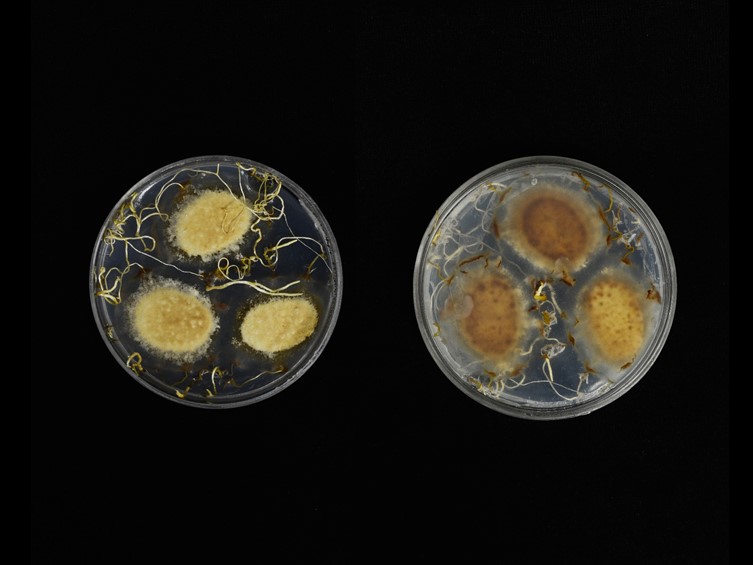

Habitat:
Leaf litter.
Host:
On adult worker ants (Hymenoptera).
Description:

Stromata usually single, sometimes multiple, 25–60 mm long, pale cream yellow to ochraceous yellow or orange. Fertile head terminal, ovoid to cylindrical, often citriform with a prominent, eccentric beak, 3–6 × 1–2 mm. 
Perithecia immersed obliquely, ostioles projecting, elongated flask shaped, up to 1000 μm long, 150–200 μm wide, ascomatal wall hyaline. 
Asci cylindrical, hyaline, capitate, 8-spored, up to 900 μm long, 6–8 μm wide. Ascus cap rounded, 8–9 μm long, 6.5–9.5 μm wide. 
Ascospores filiform, up to 700 μm long, multi-septate, breaking into 64 part-spores. Part-spore hyaline, fusoid, 8.5–12.5 × 1.5–2.5 μm.
Culture characteristics:
Colonies on PDA attaining a diam of 8 mm in 30 d, at first white turning to dark-white and pale-yellow, reverse cream brown, synnemata produced after 90 d with yellow color. 
Conidiogenous cells obclavate, denticles, stout, protuberant, 7–21 × 3–6.5 μm. Conidia smooth-walled, fusiform, 5.5–12 × 3–5 μm.
Species |
Strain |
Compound |
Pubchem CID |
Biological activity |
Reference |
|---|
|
Strain |
MH028141 | MH028142 |
|---|---|---|
| BBH43202 | - | - |
| BBH43204 | - | - |